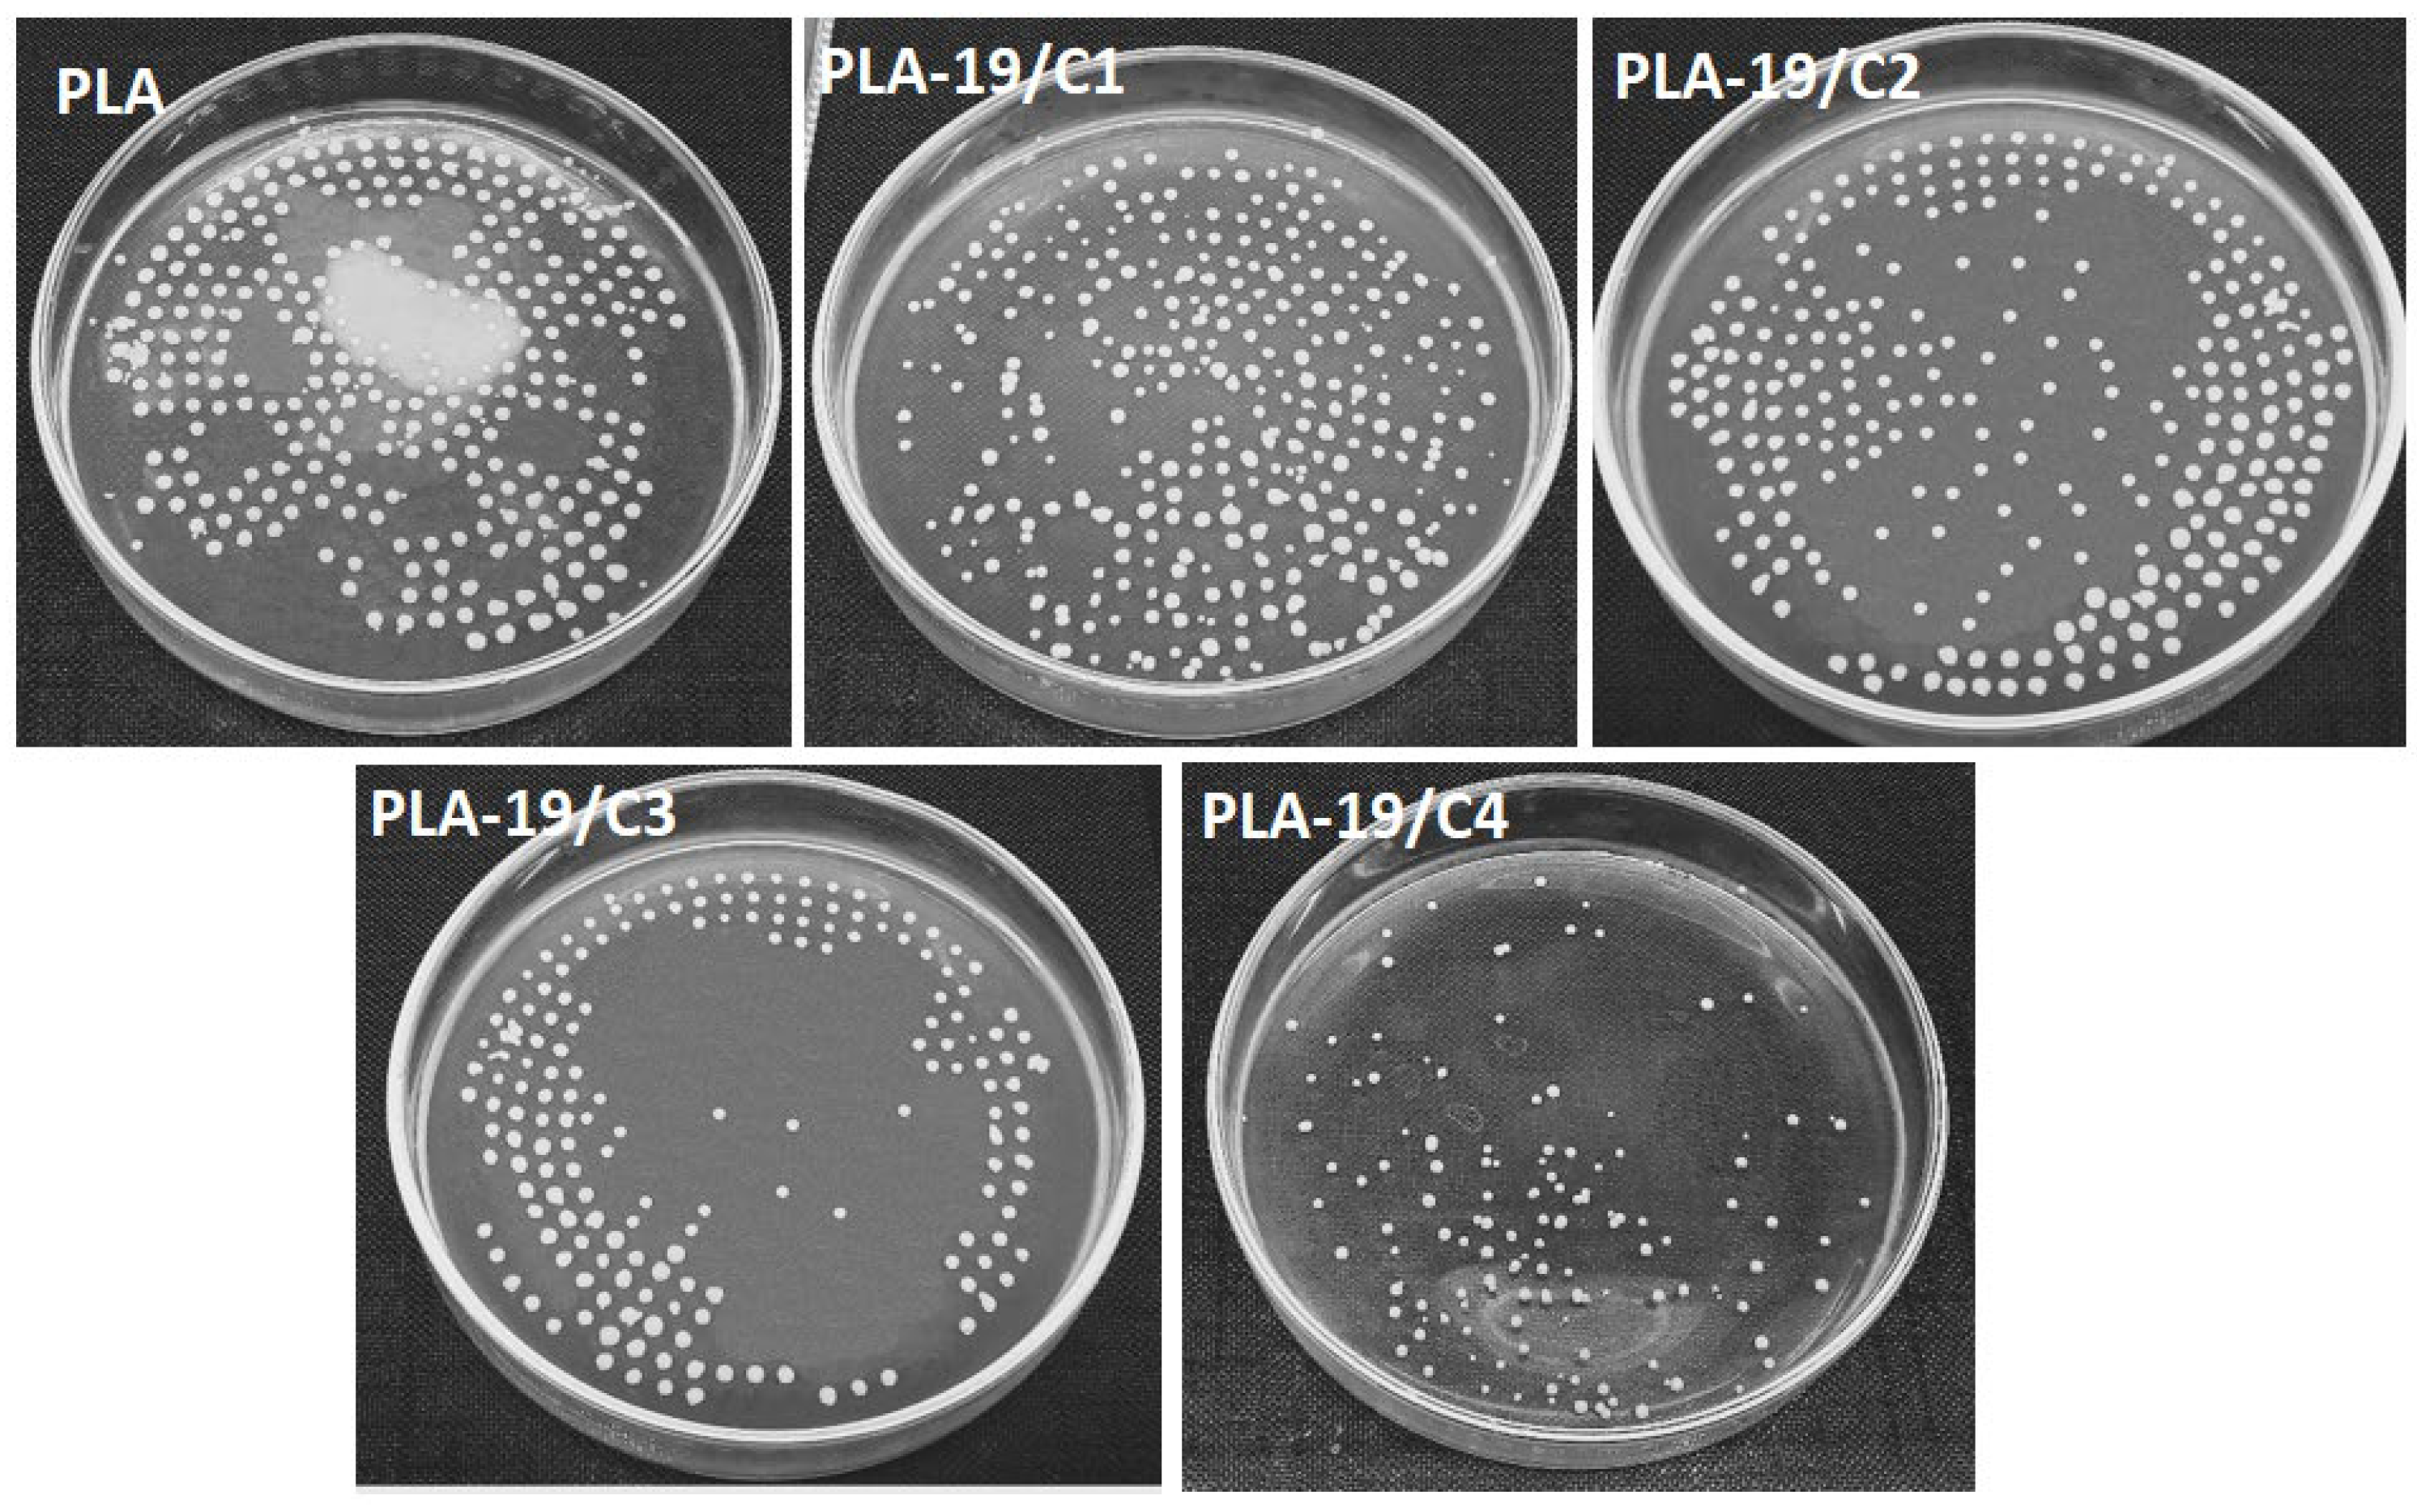
Nanomaterials 13 01195 g008 Nanomaterials 13 01195 g008

Development of Carbon-Nanodot-Loaded PLA Nanofibers and Study of Their Barrier Performance for Medical Applications
Abstract
1. Introduction
2. Materials and Methods
2.1. Materials
2.2. Synthesis of CNDs
2.3. Preparation of Solution for Electrospinning
2.4. Electrospinning of PLA
2.5. Characterization
3. Performance Testing
3.1. Antimicrobial Properties
3.2. Particulate Filtration Efficiency (PFE) Test
3.3. Differential Pressure
4. Results
4.1. SEM Analysis
4.2. Size Analysis of CNDs
4.3. Antimicrobial Testing
4.4. FTIR
4.5. TGA
4.6. Particle-Filtration Efficiency and Differential Pressure
5. Conclusions
Author Contributions
Funding
Data Availability Statement
Acknowledgments
Conflicts of Interest
References
- Personal Protective Equipment [PPE] Market Size|Trends. Available online: https://www.fortunebusinessinsights.com/personal-protective-equipment-ppe-market-102015 (accessed on 12 February 2023).
- Five Things You Should Know about Disposable Masks and Plastic Pollution|UN News. Available online: https://news.un.org/en/story/2020/07/1069151 (accessed on 24 November 2022).
- COVID-19—Wikipedia. Available online: https://en.wikipedia.org/wiki/COVID-19 (accessed on 9 January 2022).
- First COVID-19 Case Could Have Emerged in China in Oct 2019—Study|Reuters. Available online: https://www.reuters.com/world/china/first-covid-19-case-could-have-hit-china-oct-2019-study-2021-06-25/ (accessed on 9 January 2022).
- WHO Director-General’s Opening Remarks at the Media Briefing on COVID-19—11 March 2020. Available online: https://www.who.int/director-general/speeches/detail/who-director-general-s-opening-remarks-at-the-media-briefing-on-covid-19---11-march-2020 (accessed on 9 January 2022).
- Morawska, L.; Milton, D. It is time to address airborne transmission of COVID-19. Clin. Infect. Dis. 2020, 71, 2311–2313. [Google Scholar] [PubMed]
- Coronavirus Disease (COVID-19): How Is It Transmitted? Available online: https://www.who.int/news-room/questions-and-answers/item/coronavirus-disease-covid-19-how-is-it-transmitted (accessed on 9 January 2022).
- The Environmental Toll of Disposable Masks|MIT News|Massachusetts Institute of Technology. Available online: https://news.mit.edu/2021/covid-masks-environment-0720 (accessed on 24 November 2022).
- Saliu, F.; Veronelli, M.; Raguso, C.; Barana, D.; Galli, P.; Lasagni, M. The release process of microfibers: From surgical face masks into the marine environment. Environ. Adv. 2021, 4, 100042. [Google Scholar] [CrossRef]
- Munir, M.U.; Mikucioniene, D.; Khanzada, H.; Khan, M.Q. Development of Eco-Friendly Nanomembranes of Aloe vera/PVA/ZnO for Potential Applications in Medical Devices. Polymers 2022, 14, 1029. [Google Scholar] [CrossRef] [PubMed]
- Das, O.; Neisiany, R.E.; Capezza, A.J.; Hedenqvist, M.S.; Försth, M.; Xu, Q.; Jiang, L.; Ji, D.; Ramakrishna, S. The need for fully bio-based facemasks to counter coronavirus outbreaks: A perspective. Sci. Total Environ. 2020, 736, 139611. [Google Scholar] [CrossRef] [PubMed]
- Tiliket, G.; Le Sage, D.; Moules, V.; Rosa-Calatrava, M.; Lina, B.; Valleton, J.; Nguyen, Q.; Lebrun, L. A new material for airborne virus filtration. Chem. Eng. J. 2011, 173, 341–351. [Google Scholar] [CrossRef]
- Patil, N.A.; Gore, P.M.; Prakash, N.J.; Govindaraj, P.; Yadav, R.; Verma, V.; Shanmugarajan, D.; Patil, S.; Kore, A.; Kandasubramanian, B. Needleless electrospun phytochemicals encapsulated nanofibre based 3-ply biodegradable mask for combating COVID-19 pandemic. Chem. Eng. J. 2021, 416, 129152. [Google Scholar] [CrossRef] [PubMed]
- Choi, S.; Jeon, H.; Jang, M.; Kim, H.; Shin, G.; Koo, J.M.; Lee, M.; Sung, H.K.; Eom, Y.; Yang, H.; et al. Biodegradable, Efficient, and Breathable Multi-Use Face Mask Filter. Adv. Sci. 2021, 8, 2003155. [Google Scholar] [CrossRef] [PubMed]
- Wang, Z.; Pan, Z.; Wang, J.; Zhao, R. A Novel Hierarchical Structured Poly(lactic acid)/Titania Fibrous Membrane with Excellent Antibacterial Activity and Air Filtration Performance. J. Nanomater. 2016, 2016, 6272983. [Google Scholar] [CrossRef]
- He, H.; Gao, M.; Illés, B.; Molnar, K. 3D Printed and electrospun, transparent, hierarchical polylactic acid mask nanoporous filter. Int. J. Bioprint. 2020, 6, 278. [Google Scholar] [CrossRef] [PubMed]
- Kadam, V.; Truong, Y.B.; Schutz, J.; Kyratzis, I.L.; Padhye, R.; Wang, L. Gelatin/β–Cyclodextrin Bio–Nanofibers as respiratory filter media for filtration of aerosols and volatile organic compounds at low air resistance. J. Hazard. Mater. 2021, 403, 123841. [Google Scholar] [CrossRef] [PubMed]
- Al-Hazeem, N. Manufacture of fibroustructure facemask to protect against coronavirus using electrospinning. Med. Res. Chron. 2021, 8, 103–110. [Google Scholar] [CrossRef]
- Dong, X.; Liang, W.; Meziani, M.J.; Sun, Y.; Yang, L. Carbon Dots as Potent Antimicrobial Agents. Theranostics 2020, 10, 671. [Google Scholar] [CrossRef] [PubMed]
- Meziani, M.J.; Dong, X.; Zhu, L.; Jones, L.P.; LeCroy, G.E.; Yang, F.; Wang, S.; Wang, P.; Zhao, Y.; Yang, L.; et al. Visible-Light-Activated Bactericidal Functions of Carbon ‘quantum’ Dots. ACS Appl. Mater. Interfaces 2016, 8, 10761–10766. [Google Scholar] [CrossRef] [PubMed]
- Zubir, A.A.; Khairunnisa, M.P.; Surib, N.A.; NorRuwaida, J.; Bin Ali, A.H.; Rashid, M. Electrospinning of PLA with DMF: Effect of polymer concentration on the bead diameter of the electrospun fibre. IOP Conf. Ser. Mater. Sci. Eng. 2020, 778, 012087. [Google Scholar] [CrossRef]
- Beads Formation in Electrospinning. Available online: http://electrospintech.com/beads.html#.Y9kN8nZBy5d (accessed on 31 January 2023).
- Angammana, C.J. Analysis of the Effects of Solution and Process Parameters on the Electrospinning Process and Nanofibre Morphology. IEEE Trans. Ind. Appl. 2011, 47, 1109–1117. [Google Scholar] [CrossRef]
- Nayak, R.; Padhye, R.; Kyratzis, I.L.; Truong, Y.B.; Arnold, L. Effect of viscosity and electrical conductivity on the morphology and fiber diameter in melt electrospinning of polypropylene. Text. Res. J. 2013, 83, 606–617. [Google Scholar] [CrossRef]
- Kleanthous, C.; Armitage, J.P. The bacterial cell envelope. Philos. Trans. R. Soc. B Biol. Sci. 2015, 370, 1–17. [Google Scholar] [CrossRef] [PubMed]
- Mai-Prochnow, A.; Clauson, M.; Hong, J.; Murphy, A.B. Gram positive and Gram negative bacteria differ in their sensitivity to cold plasma. Sci. Rep. 2016, 6, 38610. [Google Scholar] [CrossRef] [PubMed]

| * Sample Number | Concentration of PLA (%, w/v) | Concentration of CNDs (%) | Viscosity (mPa·s) | Conductivity (µS·cm) |
|---|---|---|---|---|
| PLA-12 | 12 | – | 177 | 4 |
| PLA-15 | 15 | – | 230 | 6 |
| PLA-17 | 17 | – | 285 | 8 |
| PLA-17/C1 | 17 | 1 | 288 | 450 |
| PLA-17/C2 | 17 | 2 | 291 | 666 |
| PLA-17/C3 | 17 | 3 | 296 | 1020 |
| PLA-17/C4 | 17 | 4 | 305 | 1260 |
| PLA-19 | 19 | – | 335 | 12 |
| PLA-19/C1 | 19 | 1 | 339 | 465 |
| PLA-19/C2 | 19 | 2 | 345 | 702 |
| PLA-19/C3 | 19 | 3 | 351 | 1065 |
| PLA-19/C4 | 19 | 4 | 358 | 1290 |
| Sample | % PLA | % CNDs | Electrospinning Time (min) | Weight Add-On (mg/cm2) | Particle-Filtration Efficiency (%) | Differential Pressure (Pa/cm2) |
|---|---|---|---|---|---|---|
| PLA-19/C4 | 19 | 4% | 30 | 0.149 | 80.0 | Over range |
| 60 | 0.298 | 85.3 | 33.6 | |||
| 90 | 0.447 | 96.5 | 39.0 | |||
| 120 | 0.596 | 100 | Over range | |||
| Meltblown sheet | 1.78 | 95. | 38.5 |
Disclaimer/Publisher’s Note: The statements, opinions and data contained in all publications are solely those of the individual author(s) and contributor(s) and not of MDPI and/or the editor(s). MDPI and/or the editor(s) disclaim responsibility for any injury to people or property resulting from any ideas, methods, instructions or products referred to in the content. |
© 2023 by the authors. Licensee MDPI, Basel, Switzerland. This article is an open access article distributed under the terms and conditions of the Creative Commons Attribution (CC BY) license (https://creativecommons.org/licenses/by/4.0/).
Share and Cite
Munir, M.U.; Mayer-Gall, T.; Gutmann, J.S.; Ali, W.; Etemad-Parishanzadeh, O.; Khanzada, H.; Mikučioniene, D. Development of Carbon-Nanodot-Loaded PLA Nanofibers and Study of Their Barrier Performance for Medical Applications. Nanomaterials 2023, 13, 1195. https://doi.org/10.3390/nano13071195
Munir MU, Mayer-Gall T, Gutmann JS, Ali W, Etemad-Parishanzadeh O, Khanzada H, Mikučioniene D. Development of Carbon-Nanodot-Loaded PLA Nanofibers and Study of Their Barrier Performance for Medical Applications. Nanomaterials. 2023; 13(7):1195. https://doi.org/10.3390/nano13071195
Chicago/Turabian StyleMunir, Muhammad Usman, Thomas Mayer-Gall, Jochen S. Gutmann, Wael Ali, Omid Etemad-Parishanzadeh, Haleema Khanzada, and Daiva Mikučioniene. 2023. "Development of Carbon-Nanodot-Loaded PLA Nanofibers and Study of Their Barrier Performance for Medical Applications" Nanomaterials 13, no. 7: 1195. https://doi.org/10.3390/nano13071195
APA StyleMunir, M. U., Mayer-Gall, T., Gutmann, J. S., Ali, W., Etemad-Parishanzadeh, O., Khanzada, H., & Mikučioniene, D. (2023). Development of Carbon-Nanodot-Loaded PLA Nanofibers and Study of Their Barrier Performance for Medical Applications. Nanomaterials, 13(7), 1195. https://doi.org/10.3390/nano13071195

